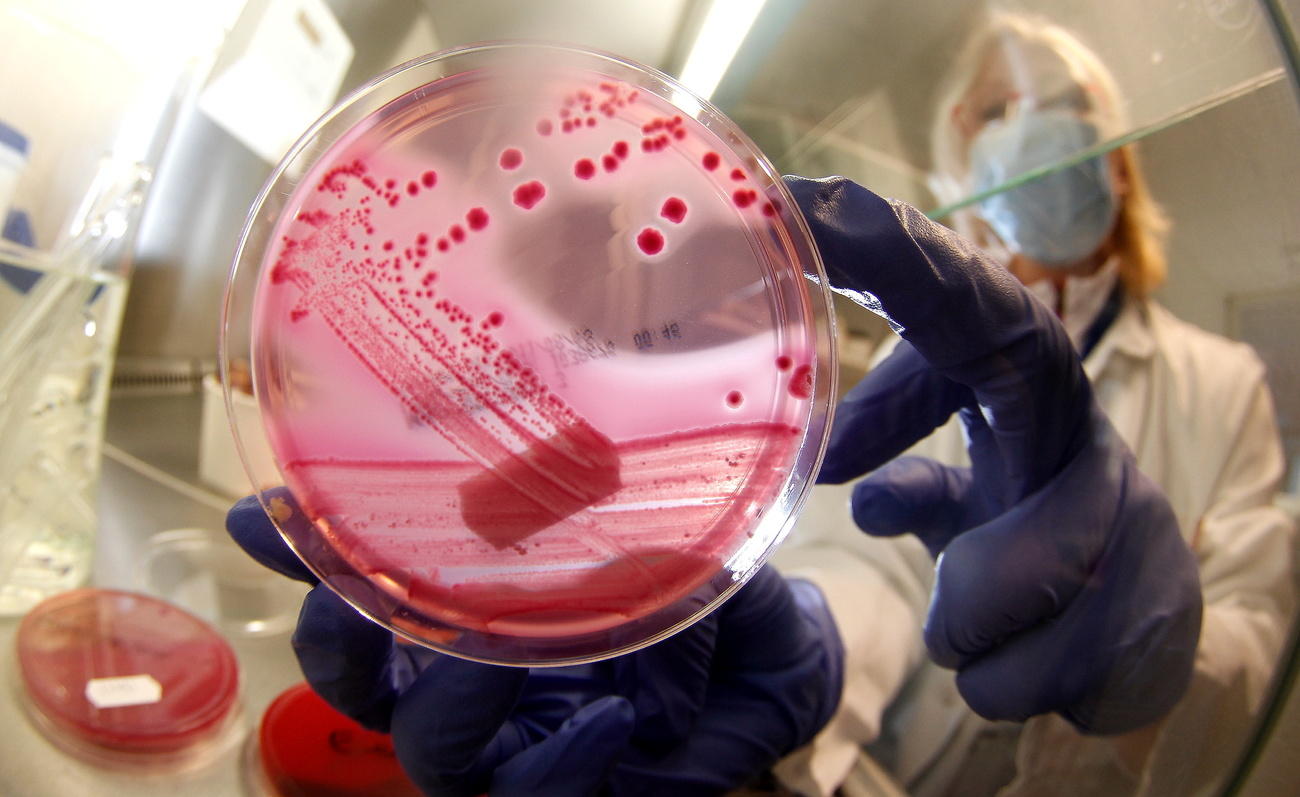

Пандемия коронавируса наносит удар по рынку антибиотиков

Осиновый кол, чеснок, серебряная пуля? Что угодно, но лекарство, а потом и вакцина против осложнений, связанных с коронавирусом, должны быть найдены, и как можно скорее. Недостатка инвестиций в эту сферу пока нет. При этом некоторые мировые эксперты в области здравоохранения предупреждают, что пандемия коронавируса может заметно усугубить уже и без того обостряющийся кризис на рынке антибиотиков. Одно из самых ранних обследований пациентов с Covid-19 в китайском Ухане, эпицентре вспышки коронавирусной инфекции, показало, что некоторые пациенты, и прежде всего особенно тяжелые больные, изначально страдали вторичными бактериальными инфекциями.
Им назначались антибиотики, но, как указано в исследовании, высокая степень лекарственной устойчивости многих бактерий, особенно грамотрицательных, заметно повышает риск септического шока у таких пациентов. Антибиотики бессильныВнешняя ссылка против Covid-19, но они являются важной линией защиты от вторичных бактериальных инфекцийВнешняя ссылка, таких как вентиляторно-ассоциированная пневмония, инфекции мочевыводящих путей и сепсис, которые весьма часто появляются у людей во время длительного пребывания в отделениях интенсивной терапии.
Особенно такие осложнения проявляются у лиц со слабой иммунной системой. Весь мир ищет средство от коронавируса, забывая об антибиотиках. «Сейчас мы не имеем ни малейшего представления о том, как выглядит ситуация со спросом и предложением на рынке антибиотиков. Мы не знаем, какие антибиотики используются для лечения больных коронавирусом и где есть какие проблемы», — говорит Маника Баласегарам (Manica Balasegaram), врач, возглавляющая расположенное в Женеве «Глобальное партнерство по исследованиям и развитию антибиотиков» (Global Antibiotic Research and Development Partnership, GARDPВнешняя ссылка).

Показать больше
Швейцария не намерена вводить экспортные ограничения
Эта структура как раз занимается самыми уязвимыми группами населения, наиболее страдающими сейчас от коронавируса. «При вспышках любых заболеваний нам все равно требуются такие базовые лекарства, как антибиотики», -рассказала М. Баласегарам в интервью порталу SWI swissinfo.ch. «Больничные инфекции будут сейчас шириться и расти из-за сложной, хаотичной ситуации в клиниках, так как медицинский персонал часто просто не успевает менять перчатки в перерывах между уходом за разными пациентами».
«Несмотря на всю текущую неопределенность»
Все это не было бы особой проблемой, если бы не печальное состояние рынка антибиотиков. Нехватка новых препаратов и лекарственная устойчивостьВнешняя ссылка бактерий по отношению к старым видам таких лекарств растут по данным Всемирной организации здравоохранения очень быстро. По оценкам ВОЗ, заболевания, возникшие в ситуации лекарственной устойчивости старых методов лечения могут стать причиной дополнительно 10 миллионов смертей в год в период до 2050 года. Опрос лидеров биофармацевтической промышленности, опубликованный в начале 2020 года, показал, что 47% из в общей сложности 65 компаний-респондентов уже столкнулись с нарушением цепочек поставок в области антибиотиков.
В условиях, когда все больше стран закрывают свои границы, вводят торговые ограничения (в Индии) и все грубее нарушают производственные нормы (в Китае), растет обеспокоенность экспертов в связи с тем, что в ближайшем будущем удовлетворение постоянно растущего спроса на эффективные антибиотики может оказаться еще более трудным делом, чем еще несколько лет назад. Энеа Мартинелли (Enea Martinelli), главный фармацевт сети клиник FMI в швейцарском Интерлакене (Interlaken), рассказал порталу SWI swissinfo.ch, что в Швейцарии поставки антибиотиков становятся более организованными, и проблемой это не является. Но она не знает, что будет через несколько месяцев. «Пандемия точно окажет влияние на поставки лекарств, но мы пока не знаем, какие именно это будут препараты», — говорит Э. Мартинелли.
Компания SandozВнешняя ссылка, дочернее подразделение концерна Novartis и крупнейший в мире производитель непатентованных антибиотиков, сообщила SWI swissinfo.ch, что в настоящее время она не предвидит перебоев в цепочке поставок, учитывая решительные меры правительства и объемы сделанных ранее запасов. Однако ситуация очень динамична, все меняется каждый день и есть аспекты и факторы, учесть которые просто невозможно. В конце февраля 2020 года компания объявила, что будет поддерживать цены на свои основные лекарственные средства на стабильном уровне, даже несмотря на всю нынешнюю неопределенность.
Вялотекущий кризис
Эксперты уже много лет предупреждают, что рынок антибиотиков находится в неудовлетворительном состоянии. Антибиотики являются одним из старейших лекарств в арсенале человека с момента чудотворного открытия пенициллина, но их чрезмерное использование и даже злоупотребление ими на протяжении последних десятилетий лет привело к тому, что бактерии начали в ответ накапливать свои собственные защитные силы. Это привело к острой необходимости в новых антибиотиках, против которых еще не возникло лекарственной резистентности.

Показать больше
Швейцарские ученые синтезировали качественно новые антибиотики
Марк Гитцингер (Marc Gitzinger), генеральный директор швейцарского биотехнологического стартапа Bioversys, говорит, что его компания работала над тем, чтобы «предложить рынку антибиотики по низкой цене, что было бы возможно при условии значительных объёмов поставок, но в последнее время ситуация изменилась. Врачи стали более внимательно относиться к назначению антибиотиков, прибегая к их помощи только в тех случаях, когда это действительно необходимо».
Компания Bioversys работает над синтезом антибиотика, подходящего для борьбы с высокорезистентными грамотрицательными бактериальными инфекциями в клиниках и больницах, где смертность от таких заражений достигает 50%. Предполагалось, что в конце 2020 года препарат будет предложен для клинических тестовых испытаний, но теперь М. Гитцингер опасается, что его проект будет отодвинут на задний план с учетом того, что органы ЕС и США, выдающие лицензии на производство лекарственных препаратов, будут полностью поглощены коронавирусом. В итоге рынок переполняется несертифицированными препаратами, спрос на них в странах с развивающейся экономикой растет, общие цены падают.
Из-за этого многие компании просто уже ушли с этого рынка, настолько невыгодно стало заниматься антибиотиками. Оценка состояния примерно 30-ти фармацевтических компаний показала, что исследования и разработки в области перспективных антибиотиков все больше концентрируются в руках только нескольких компаний. Во время Всемирного экономического форума в Давосе Джей Айер (Jay Iyer) возглавляющий фонд «Доступ к лекарствам» (Access to Medicines FoundationВнешняя ссылка), предупредил, что «мы полагаемся сейчас на очень небольшое количество компаний, которые потом будут держать под контролем все мировые поставки антибиотиков».
Несколько крупных фармацевтических компаний, включая компании Novartis и Allergan, недавно объявили о том, что они прекращают исследования в области антибиотиков, а два стартапа по производству антибиотиков в прошлом году вообще обанкротились. Компания Roche, швейцарский фармацевтический гигант из Базеля, прекратила производство антибиотиков еще в 1990-е годы, полностью перенастроив свою деятельность в этой области.
Узкие места
«Мы ведь предупреждали, что ситуация с антибиотиками может стать проблемой», — говорит Э. Мартинелли. Четыре года назад, реагируя на тот факт, что производство антибиотиков во все большей степени сейчас концентрируется в Азии, он открыл веб-сайт drughortage.chВнешняя ссылка, с тем чтобы отслеживать ситуацию с нехваткой лекарств на мировом рынке, многие из которых являются антибиотиками.

Показать больше
Прививочный скептицизм — феномен богатого общества?
Сейчас около 70-80% активных фармацевтических ингредиентов, необходимых для производства антибиотиков, поступают в Швейцарию из Азии, где производство обходится гораздо дешевле. Эта зависимость означает, что проблемы только на одном азиатском заводе могут привести к серьезным лакунам в снабжении и к «узким местам» в Швейцарии. Вот пример: когда закрытие китайского завода замедлило производство лекарств в ИндииВнешняя ссылка, индийское правительство приказало запретить экспорт сразу двадцати шести видов фармацевтической продукции, включая некоторые виды антибиотиков.
«Компании традиционно имеют складские запасы, которых может хватить на срок от двух до шести месяцев. Они вполне в состоянии справиться с краткосрочными перебоями в поставках. Проблема в другом: если страны начнут накапливать запасы и ограничивать экспорт, то это может привести к панике, что принесет больше вреда, чем пользы», — говорит Томас Куени (Thomas Cueni), генеральный директор «Международной федерации фармацевтических производителей и ассоциаций» (International Federation of Pharmaceutical Manufacturers and Associations).
Показать больше
Швейцарские ученые синтезировали качественно новые антибиотики
Завод компании Sandoz в Кундле (Kundl, Австрия), является единственным на данный момент заводом по производству антибиотиков, оставшимся в Европе, что, по словам самой компании, делает его «менее уязвимым перед лицом возможных сбоев в поставках». Э. Мартинелли говорит, что сейчас он ведет переговоры с компаниями отрасли в надежде, что они активизируются с целью внести свой вклад в преодоление кризиса.
«Последнее китайское предупреждение»
За последние несколько лет правительства и частные фонды заметно нарастили инвестиции в исследования и разработки новых антибиотиков, но эксперты утверждают, что все равно существовавшая ранее в этой отрасли экономическая модель разрушена окончательно. «Невозможно иметь устойчивый рынок антибиотиков в отсутствие возможности осуществлять продажи по адекватным и достойным ценам», — говорит М. Гитцингер, напоминая, что сейчас сладости в эксклюзивном шоколадном магазине в Цюрихе стоят дороже, чем, например, амоксициллин, антибиотик, используемый для лечения самых тяжелых пациентов.
Трудно привлечь инвесторов, когда нет отдачи, добавляет он. Поэтому сейчас в большинстве компаний по разработке новых лекарств работают не более 100 человек. Очень мало осталось настоящих специалистов, способных разрабатывать перспективные антибактериальные препараты. Если мы не изменим ситуацию и не вернем инвестиции в отрасль, мы в будущем потеряем еще больше талантов». Маника Баласегарам из GARDP согласна с тем, что существует острая необходимость в разработке новой экономической модели. «Нам нужны такие компании, как Sandoz. Если мы не будем инвестировать в исследования в области здравоохранения, мы будем снова и снова сталкиваться с подобными проблемами».

Показать больше
Фармацевтическая индустрия не спешит создавать вакцину от Covid-19

В соответствии со стандартами JTI
Показать больше: Сертификат по нормам JTI для портала SWI swissinfo.ch
Обзор текущих дебатов с нашими журналистами можно найти здесь. Пожалуйста, присоединяйтесь к нам!
Если вы хотите начать разговор на тему, поднятую в этой статье, или хотите сообщить о фактических ошибках, напишите нам по адресу russian@swissinfo.ch.